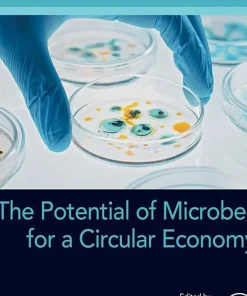
The Potential of Microbes for a Circular Economy

Shop
Showing 6301–6309 of 22654 results
Filter by price
Product categories
- Acupuncture Book (5)
- Aids Books (6)
- Allergy Books (4)
- Alzheimer Book (38)
- AMC Books (13)
- Anatomy and Physiology (181)
- Anatomy Books (519)
- Anesthesia Books (469)
- Animal Biology Books (132)
- Asthma Books (107)
- Audiology Books (78)
- Bacteriology (95)
- Biochemistry Books (856)
- Biochemistry Physics Books (25)
- Bioelectronics Books (13)
- Bioethics Books (79)
- Bioinformatics Books (113)
- Biomechanics Books (49)
- Biometrics Books (15)
- Biophysics Books (32)
- Biopolymer Books (67)
- Biostatistics Books (61)
- Biotechnology Books (373)
- Blood Transfusion Books (36)
- Cardiology Books (1649)
- Cellular and Molecular Biology Books (204)
- Dental Books (10)
- Diabetes Books (56)
- Embryology Books (58)
- Endocrinology Books (145)
- Entomology Books (34)
- Epidemiology Books (335)
- Epilepsy Books (19)
- Family Medicine Books (8)
- FCPS Books (79)
- Fisheries and Aquaculture Books (49)
- Food Industry and Nutrition Books (352)
- Forensic Medicine Books (124)
- Gene Therapy Books (13)
- Genomics Books (23)
- Gynaecology Books (91)
- Histology Books (47)
- Human Genetics Books (182)
- Hygiene and Health Books (758)
- IBCLC Exam Books (9)
- Immunology Books (238)
- Infectious Disease Books (70)
- Internal Medicine Books (130)
- Laboratory Sciences Books (112)
- Medical Books (3098)
- Medical Documents books (9)
- Medical Education Books (544)
- Medical Informatics Books (39)
- Metabolics Books (19)
- Microbiology Books (167)
- MRCOG Books (39)
- Mrcp Books (29)
- Nephrology Books (393)
- Neurology Books (288)
- Non-Medical (5416)
- Nursing Books (1073)
- Nutrition Books (123)
- Oncology Books (269)
- Oxford Books (37)
- Paediatrics Books (69)
- Parasitology Books (17)
- Parkinson Books (4)
- Pharmacology Books (396)
- Pharmacy Books (338)
- Physiotherapy Books (13)
- Plab Books (11)
- Proteomics Books (19)
- Pulmonology Books (69)
- Regenerative Medicine Books (14)
- Rehabilitation Books (49)
- Rheumatology Books (9)
- Scrub (35)
- Sports Medicine Books (188)
- Telemedicine and Health Books (27)
- Traditional Medicine Books (78)
- Tropical Medicine Books (3)
- Urology and Nephrology Books (66)
- Uworld & Usmle Books (15)
- Veterinary and Animal Science Books (1373)
Top Rated Products
Showing 21001–21030 of 22654 results
-

The Physician Assistant Student’s Guide to the Clinical Year Emergency Medicine
د.إ256.00 Quick View Compare -

The Physics and Technology of Diagnostic Ultrasound A Practitioners Guide 2nd Edition
Call for Price Quick View Compare -

The Physics Clinical Measurement and Equipment of Anaesthetic Practice for the FRCA 2nd Edition
Call for Price Quick View Compare -

The Physics of Foraging
د.إ294.00 Quick View Compare -

The Physics of Living Processes A Mesoscopic Approach
د.إ458.00 Quick View Compare -

The Physics of Protein Structure and Dynamics
د.إ999.00 Quick View Compare -

The Physiology of Fishes
د.إ517.00 Quick View Compare -
Sale!

The Physiology of the Joints
د.إ890.00Original price was: د.إ890.00.د.إ655.00Current price is: د.إ655.00. Quick View Compare -

The Physiology of the Joints 6th Edition Vol 3 The Spinal Column Pelvic Girdle & Head
د.إ97.00 Quick View Compare -

The Picture of Dorian Gray by oscar wilde
د.إ257.00 Quick View Compare -

THE PLANT BASED COOK BOOK FOR HEALTHY EATING AND LONGEVITY Stress free meal with simple recipes to enhance your immune system
د.إ139.00 Quick View Compare -

The Plant Hormone Ethylene
د.إ882.00 Quick View Compare -

The Plant Kitchen 100 Easy Recipes for Vegan Beginners
د.إ92.00 Quick View Compare -

The Plant Paradox
د.إ249.00 Quick View Compare -

The Plant Paradox Diet for Beginners
Call for Price Quick View Compare -

The Pocket Atlas of Skeletal Muscles
د.إ105.00 Quick View Compare -
Sale!

The Pocket Guide to Critical Appraisal
د.إ1,176.00Original price was: د.إ1,176.00.د.إ90.00Current price is: د.إ90.00. Quick View Compare -

The Polar Express
د.إ80.00 Quick View Compare -

The Polaroid Book. 40th Edition
د.إ148.00 Quick View Compare -

The Political Economy of Agrarian Change in Latin America
د.إ568.00 Quick View Compare -

The Politics and Perils of Space Exploration
د.إ148.00 Quick View Compare -

The Polyandrous Queen Honey Bee
د.إ321.00 Quick View Compare -

The Portfolio Diet for Cardiovascular Disease Risk Reduction An Evidence Based Approach to Lower Cholesterol through Plant Food Consumption
Call for Price Quick View Compare -
The Potential of Microbes for a Circular Economy
د.إ1,029.00 Quick View Compare -

The Power of Habit: Why We Do What We Do in Life and Business
د.إ30.00 Quick View Compare -

The Power of Ideas A History of Technological Thoughts on Digital Economics
Call for Price Quick View Compare -

The Power of Transformation How Changing Your Smile Can Change Your Life
د.إ219.00 Quick View Compare -

The Power of Zinc Understanding the Essential Mineral for Optimal Health
د.إ168.00 Quick View Compare -

The Practical Book of Card-Making
د.إ90.00 Quick View Compare -

The Practical Playbook III Working Together to Improve Maternal Health
د.إ179.00 Quick View Compare
Recently Viewed Products
No recently viewed products to display







